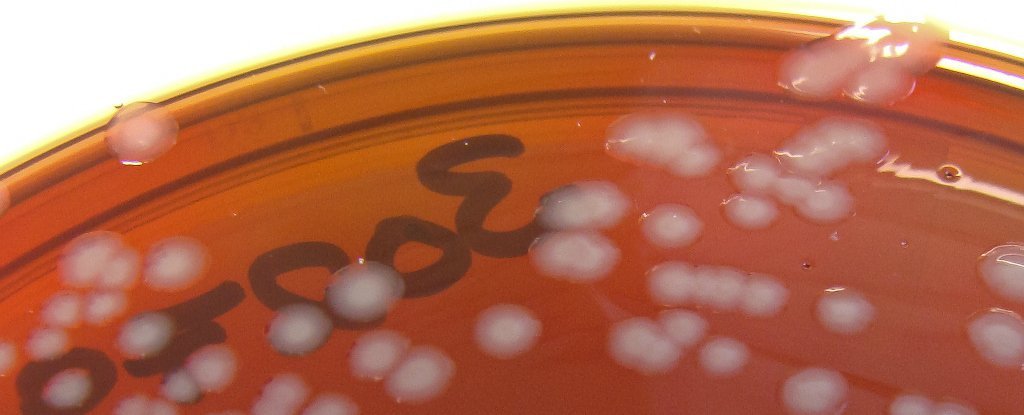
It's Official: A British Man Has Contracted The First Case of Resistant

If you are searching about The Reason Why Parmesan Cheese Is So Expensive you've came to the right page. We have 9 Images about The Reason Why Parmesan Cheese Is So Expensive like WHO Ranks the World's Most Dangerous Bacteria, Mouth bacteria can be linked to cardiovascular disease: Study - UPI.com and also Cleidopus gloriamaris - Pineapple Fish | ReefLifeSurvey.com. Here it is:
The Reason Why Parmesan Cheese Is So Expensive
 spoonfeedz.com
spoonfeedz.com Mouth Bacteria Can Be Linked To Cardiovascular Disease: Study - UPI.com
 www.upi.com
www.upi.com bacteria mouth disease upi cardiovascular linked study
Queen To Open New Artis Micro-organism Museum | NL Times
 nltimes.nl
nltimes.nl micro organism nl mite yellow
Shigella Infection - презентация онлайн
shigella infection ppt
WHO Ranks The World's Most Dangerous Bacteria
 www.popularmechanics.com
www.popularmechanics.com bacteria dangerous most science
The World's Deadliest Foods And Drinks | Lovefood.com
 www.lovefood.com
www.lovefood.com cockles clams steamed
It's Official: A British Man Has Contracted The First Case Of Resistant
www.sciencealert.com
www.sciencealert.com gonorrhea rezistenta untreatable gonorrhoea putea deveni antibioticele toate
Cleidopus Gloriamaris - Pineapple Fish | ReefLifeSurvey.com
 reeflifesurvey.com
reeflifesurvey.com gloriamaris fish pineapple reeflifesurvey shaw ian nsw australia
Biology Meets Robotics At WEF China | ETH Zürich
 ethz.ch
ethz.ch Bacteria dangerous most science. Shigella infection. Gloriamaris fish pineapple reeflifesurvey shaw ian nsw australia